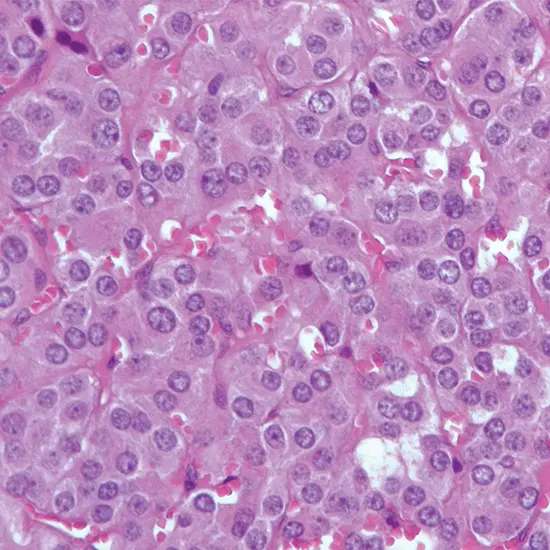

Pheochromocytoma could be an uncommon neuroendocrine tumour that is created within the chromaffin cells of the adrenal organ or, less commonly, in other parts of the thoughtful apprehensive framework.
Pheochromocytoma could be an uncommon neuroendocrine tumour that is created within the chromaffin cells of the adrenal organ or, less commonly, in other parts of the thoughtful apprehensive framework. These cells create and emit catecholamines, such as epinephrine and norepinephrine, which play a significant part in the body's "battle or flight" reaction to push.
The abundance of these hormones by pheochromocytoma can lead to a wide run of indications, counting tall blood weight, migraines, palpitations, sweating, uneasiness, and weight misfortune. Pheochromocytomas can happen at any age, but most commonly influence individuals in their 30s to 50s.
What is Pheochromocytoma?
Pheochromocytoma may be a rare sort of tumour that creates within the chromaffin cells of the adrenal organ or other parts of the thoughtful apprehensive framework. These cells create and emit catecholamines, such as epinephrine and norepinephrine, which are hormones that control the body's reaction to push.
When a pheochromocytoma tumour shapes, it can deliver over-the-top sums of these hormones, driving to an extent of indications counting tall blood weight, migraines, sweating, palpitations, uneasiness, and weight misfortune. Pheochromocytomas can happen at any age, but they are most commonly analyzed in individuals between the ages of 30 and 50.
Let's Explore the Epidemiology of Pheochromocytoma:
Pheochromocytoma could be an uncommon tumour, with an evaluated frequency of 2 to 8 cases per million individuals per year. Be that as it may, the genuine rate may be higher due to underdiagnosis or misdiagnosis.
Pheochromocytomas can happen at any age, but they are most commonly analyzed in individuals between the ages of 30 and 50. They happen similarly in men and ladies.
Around 90% of pheochromocytomas are created within the adrenal organ, with the remaining 10% happening in other parts of the body such as the thoughtful ganglia or paraganglia.
Pheochromocytoma can happen as a scattered tumour or as a portion of a genetic disorder such as numerous endocrine neoplasia sort 2 (MEN 2), von Hippel-Lindau malady, or neurofibromatosis sort 1 (NF1). In patients with genetic shapes of pheochromocytoma, the tumour may happen at a more youthful age and may be reciprocal or multifocal.
Various Causes of Pheochromocytoma:
The precise cause of pheochromocytoma isn't completely caught on, but it is thought to be related to hereditary transformations that happen in chromaffin cells of the adrenal organ or thoughtful ganglia. These transformations can cause these cells to develop and partition unusually, shaping a tumour.
In a few cases, pheochromocytoma can happen as the portion of an innate disorder, such as numerous endocrine neoplasia sort 2 (MEN 2), von Hippel-Lindau malady, or neurofibromatosis sort 1 (NF1). These disorders are caused by particular hereditary transformations that increase the hazard of creating certain sorts of tumours, counting pheochromocytoma.
Certain solutions and drugs can moreover cause indications comparable to those of pheochromocytoma by expanding the generation or discharge of catecholamines. These drugs incorporate a few antidepressants, decongestants, and illegal drugs such as cocaine or amphetamines.
In uncommon cases, pheochromocytoma may moreover be created as a result of non-inherited hereditary changes, introduction to radiation, or other natural components. Be that as it may, these cases are much less common than those related to innate disorders.
Let's learn about the Pathophysiology of Pheochromocytoma:
- Pheochromocytoma could be a tumour that is created in chromaffin cells, which are specialized cells found within the adrenal organ and the thoughtful apprehensive framework.
- These cells deliver and emit catecholamines, such as epinephrine and norepinephrine, which are hormones that direct the body's reaction to push.
- In pheochromocytoma, the tumour cells can deliver over-the-top sums of these hormones, driving to a wide extent of indications, counting tall blood weight, cerebral pain, sweating, palpitations, uneasiness, and weight misfortune.
- The side effects result from the effects of the abundance of catecholamines on different organs and frameworks within the body.
- The abundance of catecholamines can cause vasoconstriction, or narrowing of blood vessels, which can lead to tall blood weight and diminished blood stream to certain organs.
- This may result in indications such as cerebral pain, sweating, and palpitations. In expansion, the abundance of catecholamines can invigorate the heart, driving an increase in heart rate and contractility, which can contribute to side effects such as palpitations.
- Pheochromocytoma can too influence the glucose digestion system by expanding the discharge of glucose from the liver and diminishing affront discharge, which can lead to hyperglycemia or tall blood sugar levels.
- The improvement of pheochromocytoma can be related to hereditary transformations that cause anomalous development and division of chromaffin cells. In some cases, pheochromocytoma can happen as a portion of a genetic disorder, which can increase the chance of creating the tumour.
Signs and symptoms Exhibited in patients of Pheochromocytoma:
The signs and side effects of pheochromocytoma can shift broadly depending on the level and length of hormone emission, as well as the area and estimate of the tumour.
A few individuals may have no side effects, whereas others may encounter an extent of indications, which can incorporate:
- Tall blood weight (hypertension) - this is often the foremost common side effect, happening in up to 90% of cases
- Serious migraines
- Palpitations or quick pulse
- Sweating and feeling hot or cold
- Uneasiness or a sense of looming fate
- Tremors or shaking
- Weight misfortune
- Flushing or Skin discolouration
- Stomach torment or inconvenience
- Queasiness or heaving
- Clogging or the runs
- Chest torment
- Shortness of breath
- Obscured vision or other vision changes
- Shortcoming or weakness
The side effects of pheochromocytoma can be irregular, meaning they come and go, or they can be determined. In a few cases, the tumour may be found by chance, amid an imaging test or surgery for another condition.
It is imperative to note that these side effects are non-specific and can be caused by numerous other conditions, so a careful assessment by a healthcare professional is vital to decide the fundamental cause.
Diagnosis of Pheochromocytoma:
The conclusion of pheochromocytoma regularly includes a combination of clinical assessment, blood and pee tests, and imaging.
The taking after is a few common symptomatic tests utilized for pheochromocytoma:
Blood tests:
Blood tests can determine the levels of catecholamines and their breakdown items, such as metanephrines and normetanephrines, which are ordinarily lifted in individuals with pheochromocytoma.
24-hour pee collection:
A 24-hour pee collection can too degree levels of catecholamines, metanephrines, and normetanephrines. This test is more often than not more delicate than blood tests and can be utilized to affirm the conclusion of pheochromocytoma.
Imaging ponders:
Imaging ideas such as computed tomography (CT) filters, attractive reverberation imaging (MRI), or metaiodobenzylguanidine (MIBG) scintigraphy can offer assistance to visualize the tumour and decide its area and measure.
Hereditary testing:
Hereditary testing may be suggested for individuals with a family history of pheochromocytoma or who are suspected of having an innate disorder related to the tumour.
Provocative testing:
Provocative testing includes giving a pharmaceutical that invigorates the generation and discharge of catecholamines, taken after by estimation of hormone levels in blood or pee. This test can offer assistance to recognize little or irregular tumours which will not be recognized by other tests.
It is vital to note that the conclusion of pheochromocytoma can be challenging, as the indications can be compared to other conditions, and the tumour may not be perceptible on imaging ponders in a few cases. In this manner, a multidisciplinary approach including endocrinologists, radiologists, and other masters may be essential to precisely analyze and oversee this condition.
Treatment Options available for Pheochromocytoma:
The treatment of pheochromocytoma regularly includes surgical expulsion of the tumour, in case conceivable. Earlier to surgery, solutions may be utilized to control blood weight and other indications. In a few cases, extra medicines such as chemotherapy or radiation treatment may be prescribed.
Surgical resection:
The essential treatment for pheochromocytoma is surgical resection of the tumour. The surgical approach depends on the estimate and area of the tumour and may include expulsion of the complete adrenal organ (adrenalectomy) or the affected parcel of the organ (halfway adrenalectomy). In cases where the tumour cannot be evacuated surgically, other medicines such as radiation treatment or chemotherapy may be considered.
Medicines:
Sometimes in recent surgery, drugs such as alpha-blockers and beta-blockers may be utilized to control blood weight and other indications. Alpha-blockers work by widening blood vessels and lessening blood weight, whereas beta-blockers can diminish the impacts of catecholamines on the heart and other organs.
Chemotherapy:
In cases where the tumour has spread to other parts of the body, chemotherapy may be prescribed to moderate the development of the tumour and soothe side effects.
Radiation treatment:
Radiation treatment may be utilized to crush cancer cells and soothe indications in cases where the tumour cannot be evacuated surgically or has spread to other parts of the body.
Long-term follow-up:
Individuals who have experienced surgery for pheochromocytoma will require long-term follow-up to screen for a repeat of the tumour and to oversee any tireless side effects or complications. Standard blood tests and imaging may be prescribed to screen for signs of recurrence or metastasis.
It is vital to note that the treatment of pheochromocytoma ought to be individualized based on the particular characteristics of the tumour and the general well-being of the understanding. A multidisciplinary approach including endocrinologists, specialists, and other pros may be fundamental to creating an ideal treatment arrangement for each person's case.
Complications of Pheochromocytoma
Pheochromocytoma can lead to several complications, both amid and after treatment. The taking after is a few potential complications related to pheochromocytoma:
Hypertensive emergency
Uncontrolled discharge of catecholamines can cause sudden and serious rises in blood weight, which can lead to hypertensive emergencies. This may be a life-threatening condition that requires prompt therapeutic consideration.
Cardiac complications
Pheochromocytoma can cause different cardiac complications such as arrhythmias, heart disappointment, and cardiomyopathy.
Stroke
Uncontrolled tall blood weight can increment the chance of stroke.
Metastasis
Pheochromocytoma can spread to other parts of the body, especially to the liver, lungs, and bones.
Diligent or repetitive illness
Despite effective treatment, a few individuals with pheochromocytoma may encounter diligent or repetitive maladies.
Adrenal inadequate
Surgical evacuation of the adrenal organ can result in adrenal lacking, a condition in which the body does not deliver sufficient of the hormone cortisol.
Other complications
Pheochromocytoma can moreover cause an assortment of other complications such as uneasiness, weight misfortune, sweating, cerebral pain, and gastrointestinal indications.
It is critical to note that the hazard of complications can be decreased with convenient determination and suitable treatment of pheochromocytoma. Customary follow-up and checking are too basic to distinguish and oversee any potential complications which will emerge.
Prognosis of Pheochromocytoma
- The forecast of pheochromocytoma generally depends on the arrangement of the tumour at the time of conclusion and the viability of the treatment. In common, the guess for pheochromocytoma is favourable on the off chance that the tumour is localized and can be evacuated with surgery.
- The general 5-year survival rate for pheochromocytoma is estimated to be around 95%, which implies that 95% of individuals with pheochromocytoma are still alive five long times after determination.
- Be that as it may, this survival rate can change depending on variables such as the measure and area of the tumour, the nearness of metastases, and the age and by and large well-being of the understanding.
- In cases where the tumour has spread to other parts of the body, the forecast is by and large less favourable.
- The 5-year survival rate for metastatic pheochromocytoma is assessed to be around 50%, even though this could shift depending on the degree and area of the metastases.
- Standard follow-up and checking are basic for individuals who have been treated for pheochromocytoma, as the tumour can repeat in a few cases.
- It is vital to work closely with a healthcare team to oversee any continuous indications or complications and to monitor for signs of repeat.
In conclusion, pheochromocytoma could be an uncommon tumour that can cause a run of indications and complications due to the intemperate generation of catecholamines.
Opportune determination and fitting treatment, which frequently includes surgical expulsion of the tumour, can move forward the guess and diminish the risk of complications. Normal follow-up and observation are moreover fundamental to oversee any continuous side effects and distinguish any potential repeat of the tumour.
Empowered with Knowledge, Conquering Pheochromocytoma Together!









